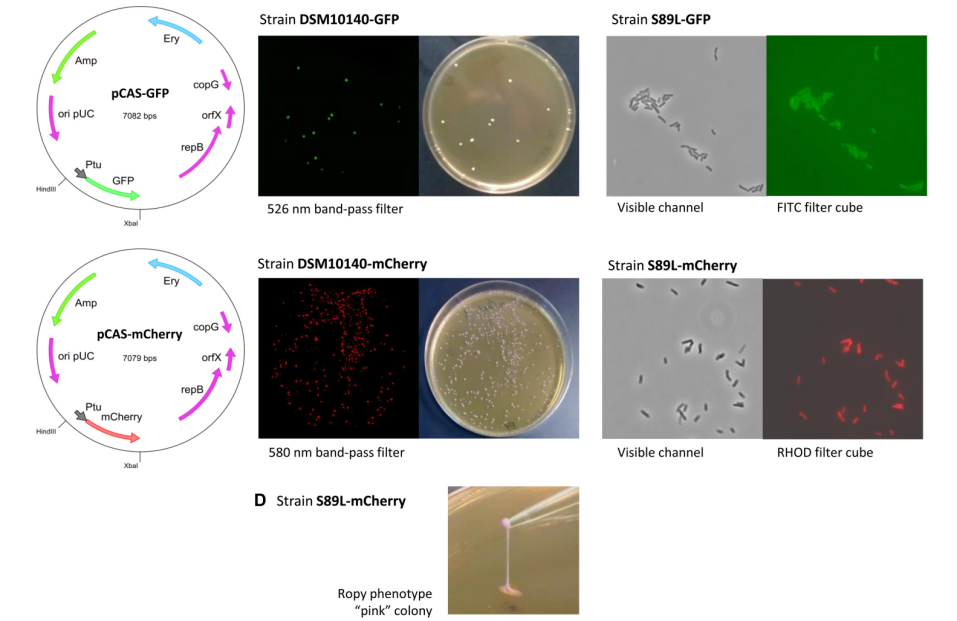
172947457776431134.png 图片11.png

以乳酸菌IPLA-R1为模板,采用特异性引物对Balat_1410的等位基因进行PCR扩增。PCR产物用ApaI和BglII酶切,克隆到之前用相同酶酶切的pJL74中,转入目标菌株,得到DSM10140的变种S89L,
然后利用特异性引物从DSM10140菌株的染色体DNA中扩增出“延伸因子Tu”启动子。用特异性引物从pVG-mCherry质粒中扩增出编码mCherry荧光蛋白的基因。尾部互补的PCR产物在1%琼脂糖凝胶中进行筛查。然后,进行剪接重叠延伸PCR,融合这两个片段。采用相同的方法将延伸因子Tu启动子与GFP基因融合。将得到的质粒转入DSM10140菌株及其变种中。

参考文献:Castro-Bravo N, Hidalgo-Cantabrana C, Rodriguez-Carvajal MA, Ruas-Madiedo P, Margolles A. Gene Replacement and Fluorescent Labeling to Study the Functional Role of Exopolysaccharides in Bifidobacterium animalis subsp. lactis. Front Microbiol. 2017 Jul 25;8:1405.
以乳酸菌IPLA-R1为模板,采用特异性引物对Balat_1410的等位基因进行PCR扩增。PCR产物用ApaI和BglII酶切,克隆到之前用相同酶酶切的pJL74中,转入目标菌株,得到DSM10140的变种S89L,
然后利用特异性引物从DSM10140菌株的染色体DNA中扩增出“延伸因子Tu”启动子。用特异性引物从pVG-mCherry质粒中扩增出编码mCherry荧光蛋白的基因。尾部互补的PCR产物在1%琼脂糖凝胶中进行筛查。然后,进行剪接重叠延伸PCR,融合这两个片段。采用相同的方法将延伸因子Tu启动子与GFP基因融合。将得到的质粒转入DSM10140菌株及其变种中。
参考文献:Castro-Bravo N, Hidalgo-Cantabrana C, Rodriguez-Carvajal MA, Ruas-Madiedo P, Margolles A. Gene Replacement and Fluorescent Labeling to Study the Functional Role of Exopolysaccharides in Bifidobacterium animalis subsp. lactis. Front Microbiol. 2017 Jul 25;8:1405.